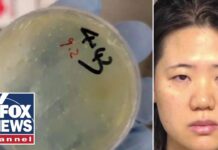
Third Chinese national accused of smuggling bio weapons in latest threat to US security, 10 June 2025

2025 4
Open/Closed: To receive testimony on the Department of Defense budget request for Fiscal Year 2026 and the Future Years Defense Program, 18 June 2025
Open/Closed: To receive testimony on the Department of Defense budget request for Fiscal Year 2026 and the Future Years Defense Program, 18 June 2025
Hearings to examine the nominations of Hung Cao, of Virginia, to be Under Secretary of the Navy, Michael Dodd, of Indiana, to be an...
Hearings to examine the nominations of Hung Cao, of Virginia, to be Under Secretary of the Navy, Michael Dodd, of Indiana, to be an...
To consider the nominations of: Vice Admiral Charles B. Cooper II, USN to be admiral and Commander, United States Central Command; and Lieutenant General...
To consider the nominations of: Vice Admiral Charles B. Cooper II, USN to be admiral and Commander, United States Central Command; and Lieutenant General...
Hearings to examine the posture of the Department of the Navy in review of the Defense Authorization Request for Fiscal Year 2026 and the...
Hearings to examine the posture of the Department of the Navy in review of the Defense Authorization Request for Fiscal Year 2026 and the...
Defending Against Drones: Setting Safeguards for Counter Unmanned Aircraft Systems Authorities, 20 May 2025
Defending Against Drones: Setting Safeguards for Counter Unmanned Aircraft Systems Authorities, 20 May 2025
To receive testimony on the posture of the Department of the Air Force in review of the Defense Authorization Request for Fiscal Year 2026...
To receive testimony on the posture of the Department of the Air Force in review of the Defense Authorization Request for Fiscal Year 2026...
To receive testimony on the Department of Energy’s atomic energy defense activities and Department of Defense nuclear weapons programs in review of the Defense...
To receive testimony on the Department of Energy’s atomic energy defense activities and Department of Defense nuclear weapons programs in review of the Defense...
Hearings to examine East Africa and the horn, focusing on a turning point or breaking point. 13 May 2025
Hearings to examine East Africa and the horn, focusing on a turning point or breaking point. 13 May 2025
A Review of the President’s Fiscal Year 2026 Budget Request for the Department of Homeland Security, 8 May 2025
A Review of the President's Fiscal Year 2026 Budget Request for the Department of Homeland Security, 8 May 2025
A Review of the President’s Fiscal Year 2026 Budget Request for the Federal Bureau of Investigation 8 May 2025
A Review of the President’s Fiscal Year 2026 Budget Request for the Federal Bureau of Investigation 8 May 2025
To consider the nominations of: Mr. Michael P. Cadenazzi, Jr. to be Assistant Secretary of Defense for Industrial Base Policy; and Vice Admiral Scott...
To consider the nominations of: Mr. Michael P. Cadenazzi, Jr. to be Assistant Secretary of Defense for Industrial Base Policy; and Vice Admiral Scott...